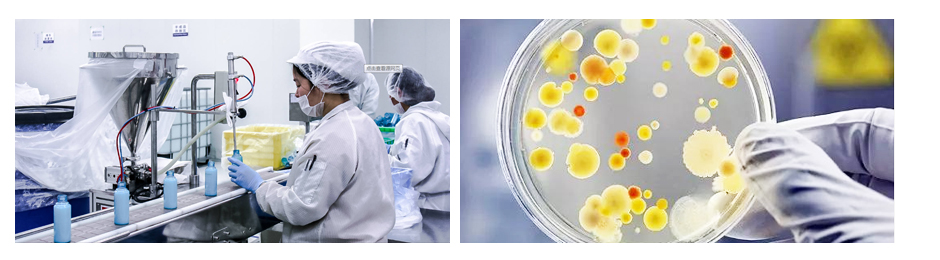

護膚品生產純水設備解決方案
- 來源:
- 君浩環保集團
- 瀏覽:
- 2716
- 發布日期:
- 2023-06-24
使用純水設備的好處

護膚品生產純水設備工藝說明

護膚品生產純水設備詳細介紹

產品特點:
1.去除懸浮顆粒和沉淀 2.除去溶解性離子 3.去除氣體 4.防止膜堵塞,保護RO膜 5.可降低能耗,節約資源

產品特點:
1.去除溶解性離子 2.去除微生物和病毒 3.提高水質 4.保障產水的穩定性 5.降低企業生產成本
護膚品生產純水設備解讀
護膚品是直接應用于皮膚的產品,因此水的純凈度對產品質量至關重要。使用純水設備可以去除水中的雜質、溶解物和微生物,確保護膚品的質量純凈。這有助于避免水中污染物對護膚品質量的影響,提供更好的護理效果,同時減少對皮膚的刺激和不良反應。
護膚品生產純水設備達標要求
化妝品生產用水標準要符合國家的相關法規標準,比如GB5749-2006 《 飲用水衛生標準 》、GB/T8538-2008 《工業用水標準》等

可根據客戶需求定制,出水達行業用水標準
君浩環保六大優勢

水處理系統一站式解決方案










 陜公網安備 61040202000640號
陜公網安備 61040202000640號